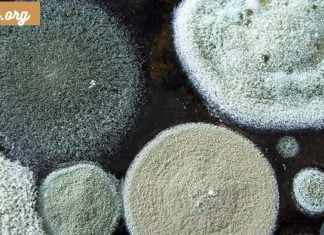
აუცილებლად საყურადღებოა.ობით მოწამვლა – დიაგნოზი და მკურნალობა

რეცეპტი,რომელიც ბევრ ქალს გაუადვილებს ყოველდღიური სახის მოვლის პროცედურებს.ბუნებრივი მათეთრებელი კრემი.
ნატურალურ იოგურტსა და ნუშის საფუძველზე დამზადებული კრემი სწრაფად აშორებს კანის მკვდარ უჯრედებს, აჯანსაღებს და აუმჯობესებს სახის ფერს, კანს გახდის უფრო ნათელს და ბზინვარებას.
ექსპერტები თვლიან,...
რა უნდა გააკეთოთ, თუ გულძმარვა გაწუხებთ.
ჭამის შემდეგ თითქმის ყველამ გრძნობს კუჭში უსიამოვნო წვის შეგრძნება.
სტატისტიკის მიხედვით, ადამიანთა დაახლოებით 20%-ს კვირაში ერთხელ მაინც აწუხებს გულძმარვა.
გულძმარვა არის დისკომფორტის ან სიცხის შეგრძნება, წვის...
ის,რაც ბევრისთვის უცნობია.ხახვის დადებითი მხარეები.
ხახვი ეკუთვნის ჯვარცმულ მცენარეთა ოჯახს და აქვს ანტიბაქტერიული თვისებები. იგი შეიცავს სენფოლ-გლიკოზიდებს, რომლებიც შეიცავს გაჯერებულ გოგირდის შემცველ ნივთიერებებს.
თავად სენფოლის გლიკოზიდები არ იწვევენ გაღიზიანებას ადამიანებში,...
ამ ვიტამინის ნაკლებობამ შეიძლება გამოიწვიოს ჯანმრთელობის გართულებები.
ყველაფერი რაც თქვენ უნდა იცოდეთ E ვიტამინის შესახებ
ვიტამინი E ასრულებს რამდენიმე მნიშვნელოვან ფუნქციას ორგანიზმში.
მისი თავისებურება ის არის, რომ ცხიმში ხსნადია.
ვიტამინ E-ს აქვს ძლიერი ანტიოქსიდანტური...
საიდან მოდის სიცივის ალერგია და როგორ გავუმკლავდეთ მას.
სიცივის ალერგიამ შეიძლება ბევრი პრობლემა გამოიწვიოს.
მაგალითად, ადამიანს არ შეუძლია ცივ ამინდში გარეთ ყოფნა ან ნაყინის ჭამა. ვის ემუქრება სიცივის ალერგიის რისკი? როგორ დავიცვათ თავი...
აწიეთ წარბები და მოიშორეთ ნაოჭები შუბლზე.
თუ თქვენ გაქვთ ჩვევა რაიმე მიზეზით ცხვირის დაჭიმვას, ნაოჭების საწინააღმდეგო ვარჯიში ნებისმიერი გზით დაგეხმარებათ შეგნებულად შეცვალოთ სახის გამომეტყველება.
შუბლზე ნაოჭების საწინააღმდეგო ვარჯიში ასწორებს ცხვირის ხიდს,...
კარგი მხედველობისთვის დღეში 10 წუთი გჭირდებათ.
თვალების ვარჯიში საოცრებაა, თუ ამას რეგულარულად აკეთებთ. შემოთავაზებული 10 სავარჯიშოდან შეგიძლიათ აირჩიოთ ხუთი, მაგრამ მთელი კომპლექსი უნდა დაუთმოთ დაახლოებით 10 წუთი ყოველდღე.
1. ორი წუთის...
ნიშნები, რომლებიც მიუთითებს მუხლის პრობლემებზე და მისი მკურნალობა.
ხშირია მუხლის დაზიანებები. ამავე დროს, მტკივნეული და უსიამოვნოა და რაც მთავარია, როგორც ექიმები აღნიშნავენ, არსებობს მთელი რიგი გამაფრთხილებელი სიგნალები და ნიშნები, რომლებიც მიუთითებს იმაზე,...
ბროკოლის მომზადების წესი თქვენი ჯანმრთელობისთვის.
რატომ უნდა დაამატოთ ბროკოლი თქვენს საკვებში
ბროკოლი მრავალი კერძის შესანიშნავი ინგრედიენტია.
იგი შეიცავს ვიტამინებისა და ქიმიურ ნაერთების მრავალფეროვნებას. ბროკოლი კარგია როგორც მოზრდილებისთვის, ასევე ბავშვებისთვის. აი, როგორ...
აუცილებლად საყურადღებოა.ობით მოწამვლა – დიაგნოზი და მკურნალობა
ობის უარყოფა ითვლება მრავალი ქრონიკული დაავადების ფაქტორად.
ობის მოწამვლის სიმპტომები ხშირად ბუნდოვანია: დაღლილობა, მეხსიერების გაძნელება, ნაწლავის დისფუნქცია, კუნთების ტკივილი.
აქედან გამომდინარე, საშიში ობის მოწამვლის ფაქტორები შეიძლება...
ლამაზი და გლუვი კანის მქონე ადამიანები ყოველთვის იპყრობენ გარშემომყოფების ყურადღებას. სახის...
ლამაზი და გლუვი კანის მქონე ადამიანები ყოველთვის იპყრობენ გარშემომყოფების ყურადღებას. აქ არის ერთ-ერთი საოცარი საშუალება: ნიღაბი, რომელიც თქვენს სახეს მისცემს სიმტკიცეს, სიგლუვეს და ბზინვარებას.
ლამაზი,...
შიის კარაქის საოცარი სარგებელი: ბუნების ძვირფასი საჩუქრები თქვენი კანისთვის.
მრავალი საუკუნის განმავლობაში აფრიკის კონტინენტის ხალხები იყენებდნენ თავისი შემადგენლობით უნიკალურ შის კარაქს მედიცინაში, კოსმეტოლოგიაში და კულინარიაშიც კი.მრავალი საუკუნის განმავლობაში, აფრიკის კონტინენტის ხალხები იყენებდნენ შის...
სამი რჩევა პროფესიონალისგან თქვენი თმის ბზინვარებისა და სიჯანსაღის შესანარჩუნებლად.
მხოლოდ სწორი ოსტატი ტრიქოლოგი გირჩევს. ეს ხრიკები ყველა ქალს შეუძლია შეასრულოს და ისიამოვნოს განსაცვიფრებელი შედეგით, როგორც შამპუნის რეკლამაში.
უკვე ერთი თვეა ვიყენებ ხრიკებს, თმა უბრალოდ...
სტომატიტი – მკურნალობა ხალხური საშუალებებით.
სტომატიტი არის პირის ღრუს ლორწოვანის ანთებითი დაზიანება.
ეს დაავადება შეიძლება განვითარდეს დამოუკიდებლად და, ამავე დროს, იყოს სხვა დაავადებების სიმპტომი, მაგალითად, სკარლეტ ცხელება ან წითელა.
სტომატიტის განვითარების...
ყველასთვის საინტერესო კანის დაავადება – დერმატიტი ,გამომწვევი მიზეზები.
დერმატიტი არის კანის ანთება, რომელიც გამოწვეულია სხვადასხვა გამღიზიანებლების ზემოქმედებით.
გარე აგენტები შეიძლება იყოს მექანიკური, ქიმიური ან ფიზიკური. გარე ფაქტორების გარდა, არის შიდა ფაქტორებიც.
ამიტომ, ენდოკრინული ან...
მე ამაზე პასუხი მივიღე: რაზე მიუთითებს სხვადასხვა ფერის გამონადენი ცხვირიდან ?
სინუსები იწმინდება ლორწოთი.
როდესაც ცხვირიდან გამონადენის სიბლანტე და ფერი იცვლება, შესაძლოა ექიმთან დაგჭირდეთ. ცხვირის ლორწო იცავს სასუნთქ სისტემას აგრესიული გარე ფაქტორებისგან, როგორიცაა ვირუსები, მტვერი, კვამლი...
მხედველობა: აი, რას უნდა მიაქციოთ ყურადღება ასაკის მატებასთან ერთად .
ასაკთან დაკავშირებული მაკულარული დეგენერაცია
ასაკთან დაკავშირებული მაკულარული დეგენერაცია ხშირია 50 წელზე უფროსი ასაკის ადამიანებში.
ეს დაავადება საკმაოდ იშვიათია ახალგაზრდებში და მისი გამომწვევი მიზეზები ჯერ კიდევ არ...
ის, რაც ბევრისთვის უცნობია. ლიმფური სისტემა: 4 მნიშვნელოვანი რამ, რაც უნდა...
ლიმფური სისტემა აუცილებელია ორგანიზმის გასაწმენდად და ინფექციებისგან დასაცავად.
ლიმფური სისტემა ორგანიზმში ძალიან მნიშვნელოვან ფუნქციას ასრულებს - შლის ტოქსინებს და ნარჩენ პროდუქტებს. სხვა სიტყვებით რომ ვთქვათ,...
საოცრად მარტივია. არაჩვეულებრივი შეფუთვები ლამაზი და მყარი კანისთვის.
ბევრმა იცის კანის მოვლის ეს მეთოდი, როგორც შეფუთვა.
როგორც წესი, მიჩვეული ვართ ამის გაკეთებას ანტიცელულიტური კრემებით, ყავის ნალექით, ზღვის მცენარეებით.
თუმცა, არსებობს უფრო საინტერესო და უჩვეულო...
აი, რა უნდა იცოდეთ.რომელი სახის კრემის გამოყენება უკეთესია ზამთარში.
ცივ სეზონზე კანს განსაკუთრებული მოვლა სჭირდება.
მკვრივი მკვებავი კრემები უნდა იქნას გამოყენებული, ხოლო მატონიზირებელი გელები და გამაგრილებელი საშუალებები ზაფხულამდე უნდა მოიხსნას.
ზამთარში გჭირდებათ კოსმეტიკა, რომელიც დაიცავს...